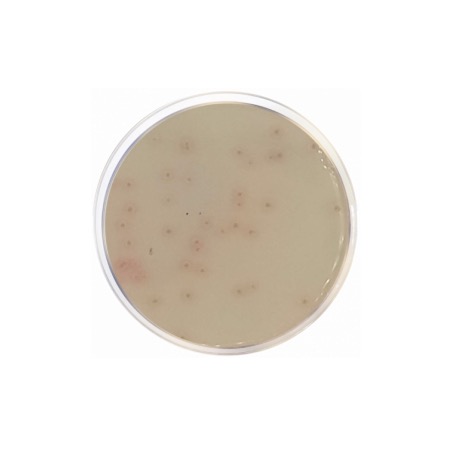
product

TSN Agar utilizes the ability of Clostridium perfringens to reduce sulfites and its resistance to specific antibiotics. The Tryptone and Yeast Extract provide a rich source of nitrogen, amino acids, and B-complex vitamins essential for the growth of fastidious Clostridia. Sodium Sulfite acts as the substrate for sulfite reduction; C. perfringens reduces sulfite to sulfide, which then reacts with Ferric Citrate to produce iron sulfide, resulting in characteristic black colonies. The medium is made highly selective by the inclusion of Neomycin and Polymyxin B, which inhibit most Enterobacteriaceae and other sulfite-reducing bacteria (such as some Bacillus species), ensuring that the black colonies observed are presumptive of C. perfringens.
Advantages
- High Specificity: The combination of Neomycin and Polymyxin B provides superior inhibition of non-target flora compared to non-selective sulfite agars.
- Rapid Results: Designed for incubation at 44–46 °C, which promotes the fast growth of C. perfringens while further inhibiting many other mesophilic bacteria.
- Clear Differentiation: The intense blackening of the colonies provides an unmistakable visual indicator of sulfite-reducing activity.
- Standardized Monitoring: Ideal for quality control in the food industry, particularly for meat and poultry products where C. perfringens is a concern.
- Reduced Background: Effectively suppresses the growth of Clostridium bifermentans and Clostridium sporogenes, which can interfere with counts on other media.
Technical specifications
| Catalogue number |
1075 |
| Brand |
Condalab |
| Application |
Selective isolation and enumeration of Clostridium perfringens |
| Typical Composition (g/L) |
Tryptone (15.0); Yeast Extract (10.0); Sodium Sulfite (1.0); Ferric Citrate (0.5); Neomycin Sulfate (0.05); Polymyxin B Sulfate (0.02); Bacteriological Agar (13.5) |
| Final pH (at 25 °C) |
7.2 ± 0.2 |
| Preparation |
40.0 g/L |
| Storage Temperature |
2 – 25 °C |
Available packaging options
| 1075 |
500 g plastic bottle |